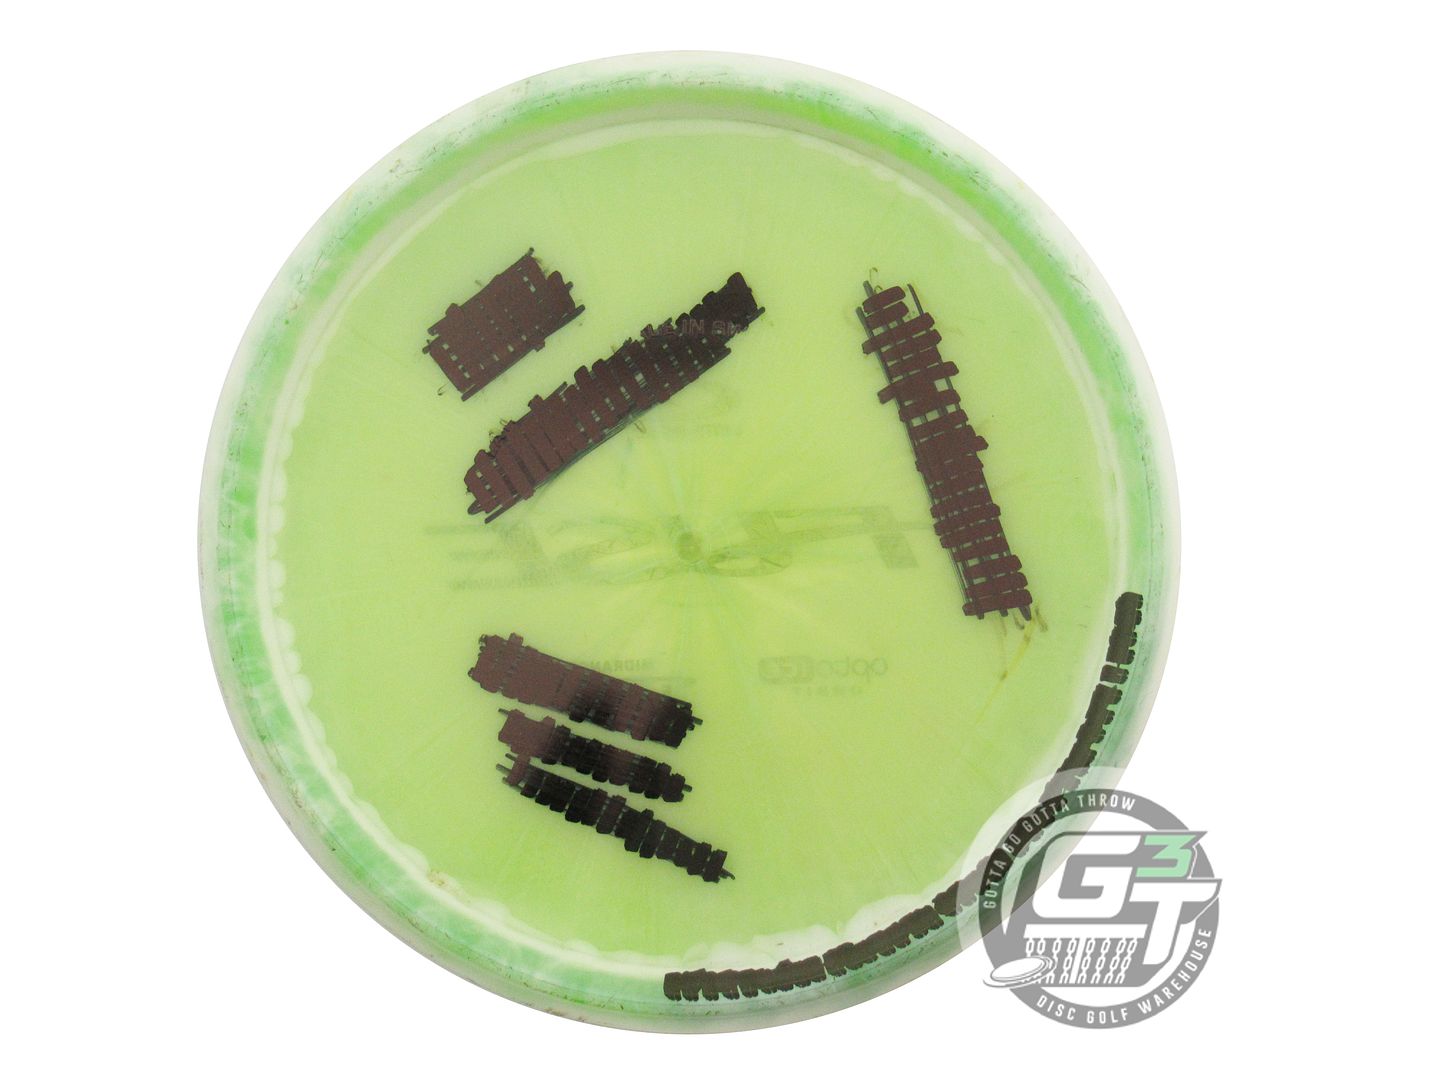
USED Latitude 64 Opto Ice Orbit Fuse 174g White-Lime Midrange Golf Disc

USED Latitude 64 Opto Ice Orbit Fuse 174g White-Lime Midrange Golf Disc
Used Discs | Sleepy Scale Rating | Details
1. This disc is used and may show minor wear from previous play. The Sleepy Scale measures both stability and condition: a lower rating indicates a more “sleepy,” worn disc, while a higher rating indicates a disc closer to new with more “awake,” responsive flight characteristics.
2. This disc is individually photographed, so you’re choosing the exact weight, color, and stamp shown above.
Only Available In Store At Our Little Canada Location:
2900 Rice Street #440, Little Canada, MN
The Fuse is the most versatile midrange driver we have ever made. It has been co-designed with our pro Jesper Lundmark. We wanted a disc that could hold curves with minimal fade at the end and are really pleased with the outcome. This superb midrange will fit in most players bags. The Fuse has a stable, predictable flight pattern up to 90 meters (300 ft)
| Speed | Glide | Turn | Fade |
| 5 | 6 | -1 | 0 |
| RNG | HSS | LSS | PWR |
| 3 | -1.5 | 1.5 | 1 |

![Lightning Sure Grip #1 Driver [Retool] Fairway Driver Golf Disc](http://gottagogottathrow.com/cdn/shop/files/LTSG-RT-_1_Driver.jpg?v=1740762223&width=1000)
